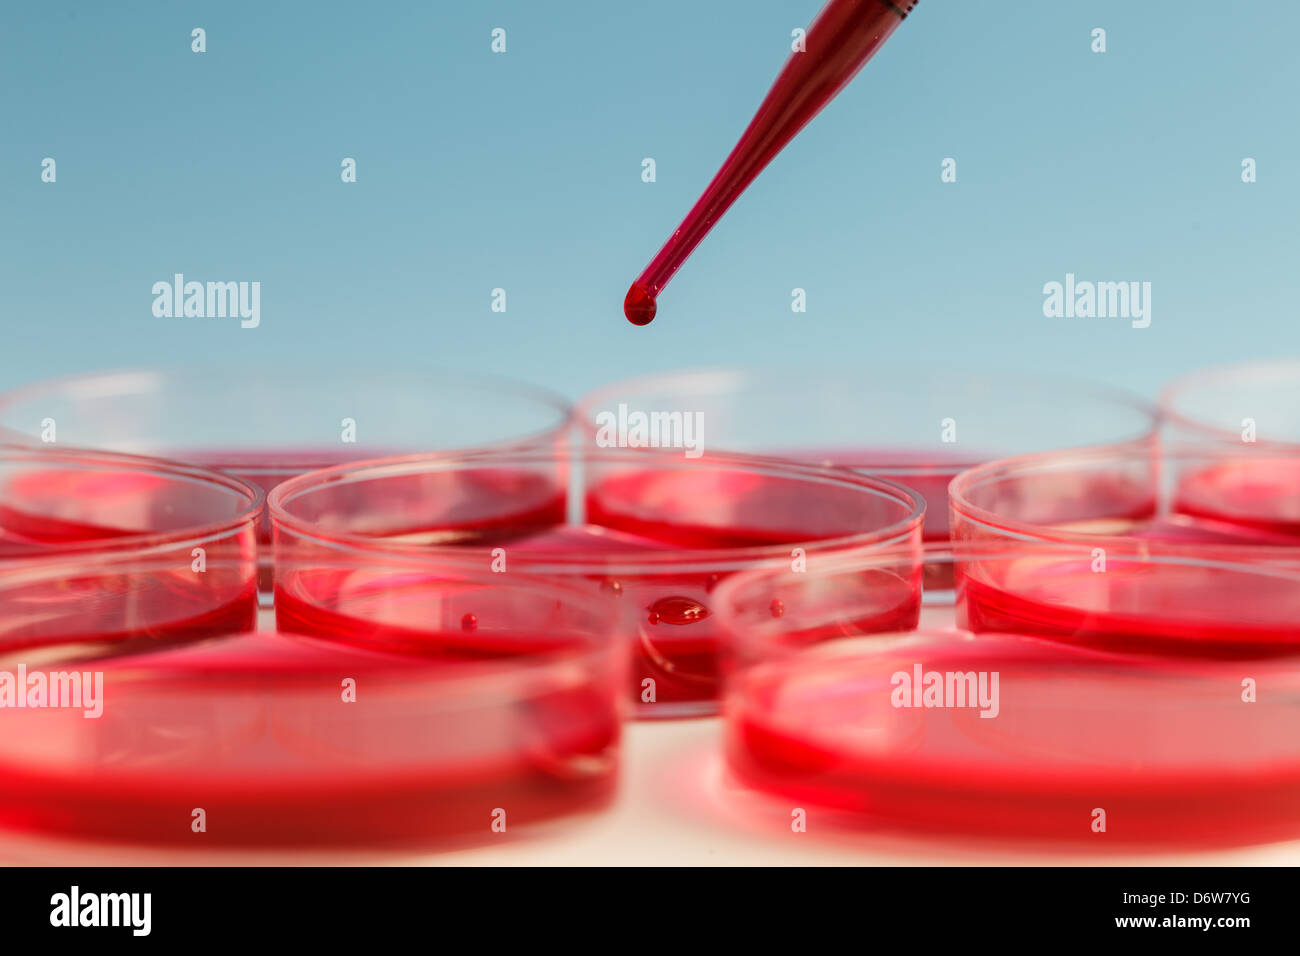
Chemie, Biologie, Chemie oder medizinische Labor Stockfoto

Schnellfilter:
Chemische biologie Stockfotos & Bilder
RF2YGC85J–Chemieflasche Labor Wissenschaft Glasbecher Behälter Messgeräte Chemische Biologie Icon Schild Form Linie Umriss Schwarz Weiß Vektor

RF2BGGW5J–Chemische Laboruntersuchungen. Pharmazie Verarbeitung und Wissenschaft medizinische Forschungslabor. Vektorbuchumschläge, Broschürenvorlage. Illustration von Pharmazie Labor Poster, medizinische Prüfung und Forschung

RF2X8EGKR–Bild von Diagrammen, Radargeräten, Karten- und Computersprache, verschiedene Wissenschaftlerinnen, die Flüssigkeit testen

RF2PK01B8–Chemie, Biologie. Wissenschaftler, der eine Probe blauer Flüssigkeit mit einer Pipette nimmt

RF2B1FBNC–Molekularmodell. Hyaluronsäuremoleküle, chemische Wissenschaft organische Molekularstruktur und reflektierende Moleküle Modelle 3D-Vektorsatz

RFPYH4YK–DNA und Neuronen, DNA, Umstrukturierung, umzuschreiben und kontinuierliche Regeneration, erhöhte Aktivität der Nervenzellen, Chromosomen und genetisches Material

RF3A63G4C–Labortests. Wissenschaftler arbeiten mit Getreideproben am grauen Tisch drinnen, Nahaufnahme

RF2XP8GGN–Reagenzgläser mit gelben Verschlüssen. Hand gezeichnete Illustration isoliert auf weißem Hintergrund für Design, Logos, Karten, Geschäft, medizinische Artikel, Lehrbücher, wra

RF2XCKY97–Seitenansicht eines stehenden Wissenschaftlers, der eine flüssige Probe mit einer Mikropipette extrahiert

RF2PK7XJ8–Chemie, Biologie. Wissenschaftler, der eine Probe blauer Flüssigkeit mit einer Pipette nimmt

RFPYH5D3–DNA und Neuronen, DNA, Umstrukturierung, umzuschreiben und kontinuierliche Regeneration, erhöhte Aktivität der Nervenzellen, Chromosomen und genetisches Material

RF2JCR752–Nahtloses Vektormuster mit DNA und Atomen auf violettem Hintergrund. Einfaches wissenschaftliches Tapetendesign. Dekorative Chemie Mode Textil.

RF3A63G44–Labortests. Wissenschaftler gießen Haferkörner in Mörtel an grauem Tisch drinnen, Nahaufnahme

RF2X8EGMH–Bild von Ladekreisen, Computersprache, kaukasischer Wissenschaftler mit Maske, der Flüssigkeit untersucht

RF2R21JG4–Chemie, Biologie. Wissenschaftler, der eine Probe blauer Flüssigkeit mit einer Pipette nimmt

RF2HNEBCC–Einfaches Vektorsymbol für Reagenzglas. Illustration Symbol Design-Vorlage für Web mobile UI-Element.

RF2F9RN89–Rote, gelbe, grüne und blaue Getränke in den Reagenzgläsern auf einem Ständer. Blauer Hintergrund dahinter.

RF2C6HYBD–3d-Molekülstruktur. Futuristischer Technologiestil. Verbindungsstruktur. 3d Vektordarstellung für Wissenschaft, Technologie, Marketing, Präsentation.

RMFRPDWF–Biologie, Biotechnologie, chemische, biologische, Chemiker, heilen, entdecken, Entdeckung, Arzt, Experiment, experimentell, Experti

RMJEBWD6–Labor, Forschung, Reagenzglas, Flüssigkeit, Chemie, Forschung, chemisches Labor, Glas, Wissenschaft, Experiment, Analysen, Biologie, chemisch, biologisch, Apotheke, Versuch, Experiment, Mikrobiologie, Medizin, Pharma, Kolben, Probe,

RF2X3BEJF–Orangefarbene, grüne, blaue und gelbe chemische Flüssigkeit, gefüllt in mehreren Petrischalen und erlenmeyerkolben. Medizinexperiment und chemischer Biologiestud

RFT5JH61–Die chemische Probe in einen Eppendorf Röhrchen mit einer chemischen Verbindung im Hintergrund pipettiert

RF3A63G3T–Labortests. Wissenschaftler mit Reagenzgläsern im Innenbereich, konzentrieren sich auf Glaswaren von Proben

RFKJM7MH–Chemisches Labor logo Vorlage. Abstrakte hexagon Vektor Schriftzug. Biologie hi-tech Technologie Logos. medizinische Geräte

RF2KFHH53–3D Bild der Skelettformel von Dioxymone - molekulare chemische Struktur von Chromone auf weißem Hintergrund isoliert

RF2HNF1PR–Einfaches Vektor-Symbol für Chemie. Illustration Symbol Design-Vorlage für Web mobile UI-Element.

RF2BNRNN1–Laborartikel für Chemikalien. Wissenschaft Laborsammlung Flaschen Mikroskop Glasröhren Biologie Vektor realistische Werkzeuge

RF2R7TMDD–Wissenschaftliches Labor generische Biologie Chemie Forschungskonzept Grafikdesign für Bannerhintergrund.

RF3D5TCW5–Chemisches Biologielabor mit vielen Glasröhren und Kolben mit blauer Flüssigkeit im Inneren, chemisches Mikrobiologielabor für medizinische Analyse Industriekonzept Backgrou

RMFRPDTF–Biologie, Biotechnologie, chemische, biologische, Chemiker, heilen, entdecken, Entdeckung, Arzt, Experiment, experimentell, Experti

RF2X3BEMP–Wissenschaftler mit weißen Handschuhen rührt die Chemikalie mit einem Glasstab um. Medizingerätes Experiment und chemisch-biologisches Studium in wissenschaftlichen Laboren

RF3A63G3R–Labortests. Wissenschaftler gießen Flüssigkeit in das Reagenzglas am grauen Tisch drinnen, Nahaufnahme

RFJGWK4R–Biologische Forschung Labor innen Vektor-Illustration. Technologiezimmer Labor für Biologie und Chemie-Experimente

RF2KFJ89G–3D Bild der Skelettformel von Methylacetat - molekulare chemische Struktur von Methylethanat isoliert auf weißem Hintergrund

RF2HNCMKB–Einfaches Vektorsymbol für Reagenzglas. Illustration Symbol Design-Vorlage für Web mobile UI-Element.

RF2BNNAMN–Wissenschaft isometrisch. Chemische Unterstützung Labor Tests Biologie Attribute wissenschaftlichen Glasröhren Medikamente Mikroskop Vektor 3d-Bilder

RF2AXFCBW–Mehrkanalpipette und Multiwell-Platten, die im mikrobiologischen Labor verwendet werden. 3D-Abbildung.